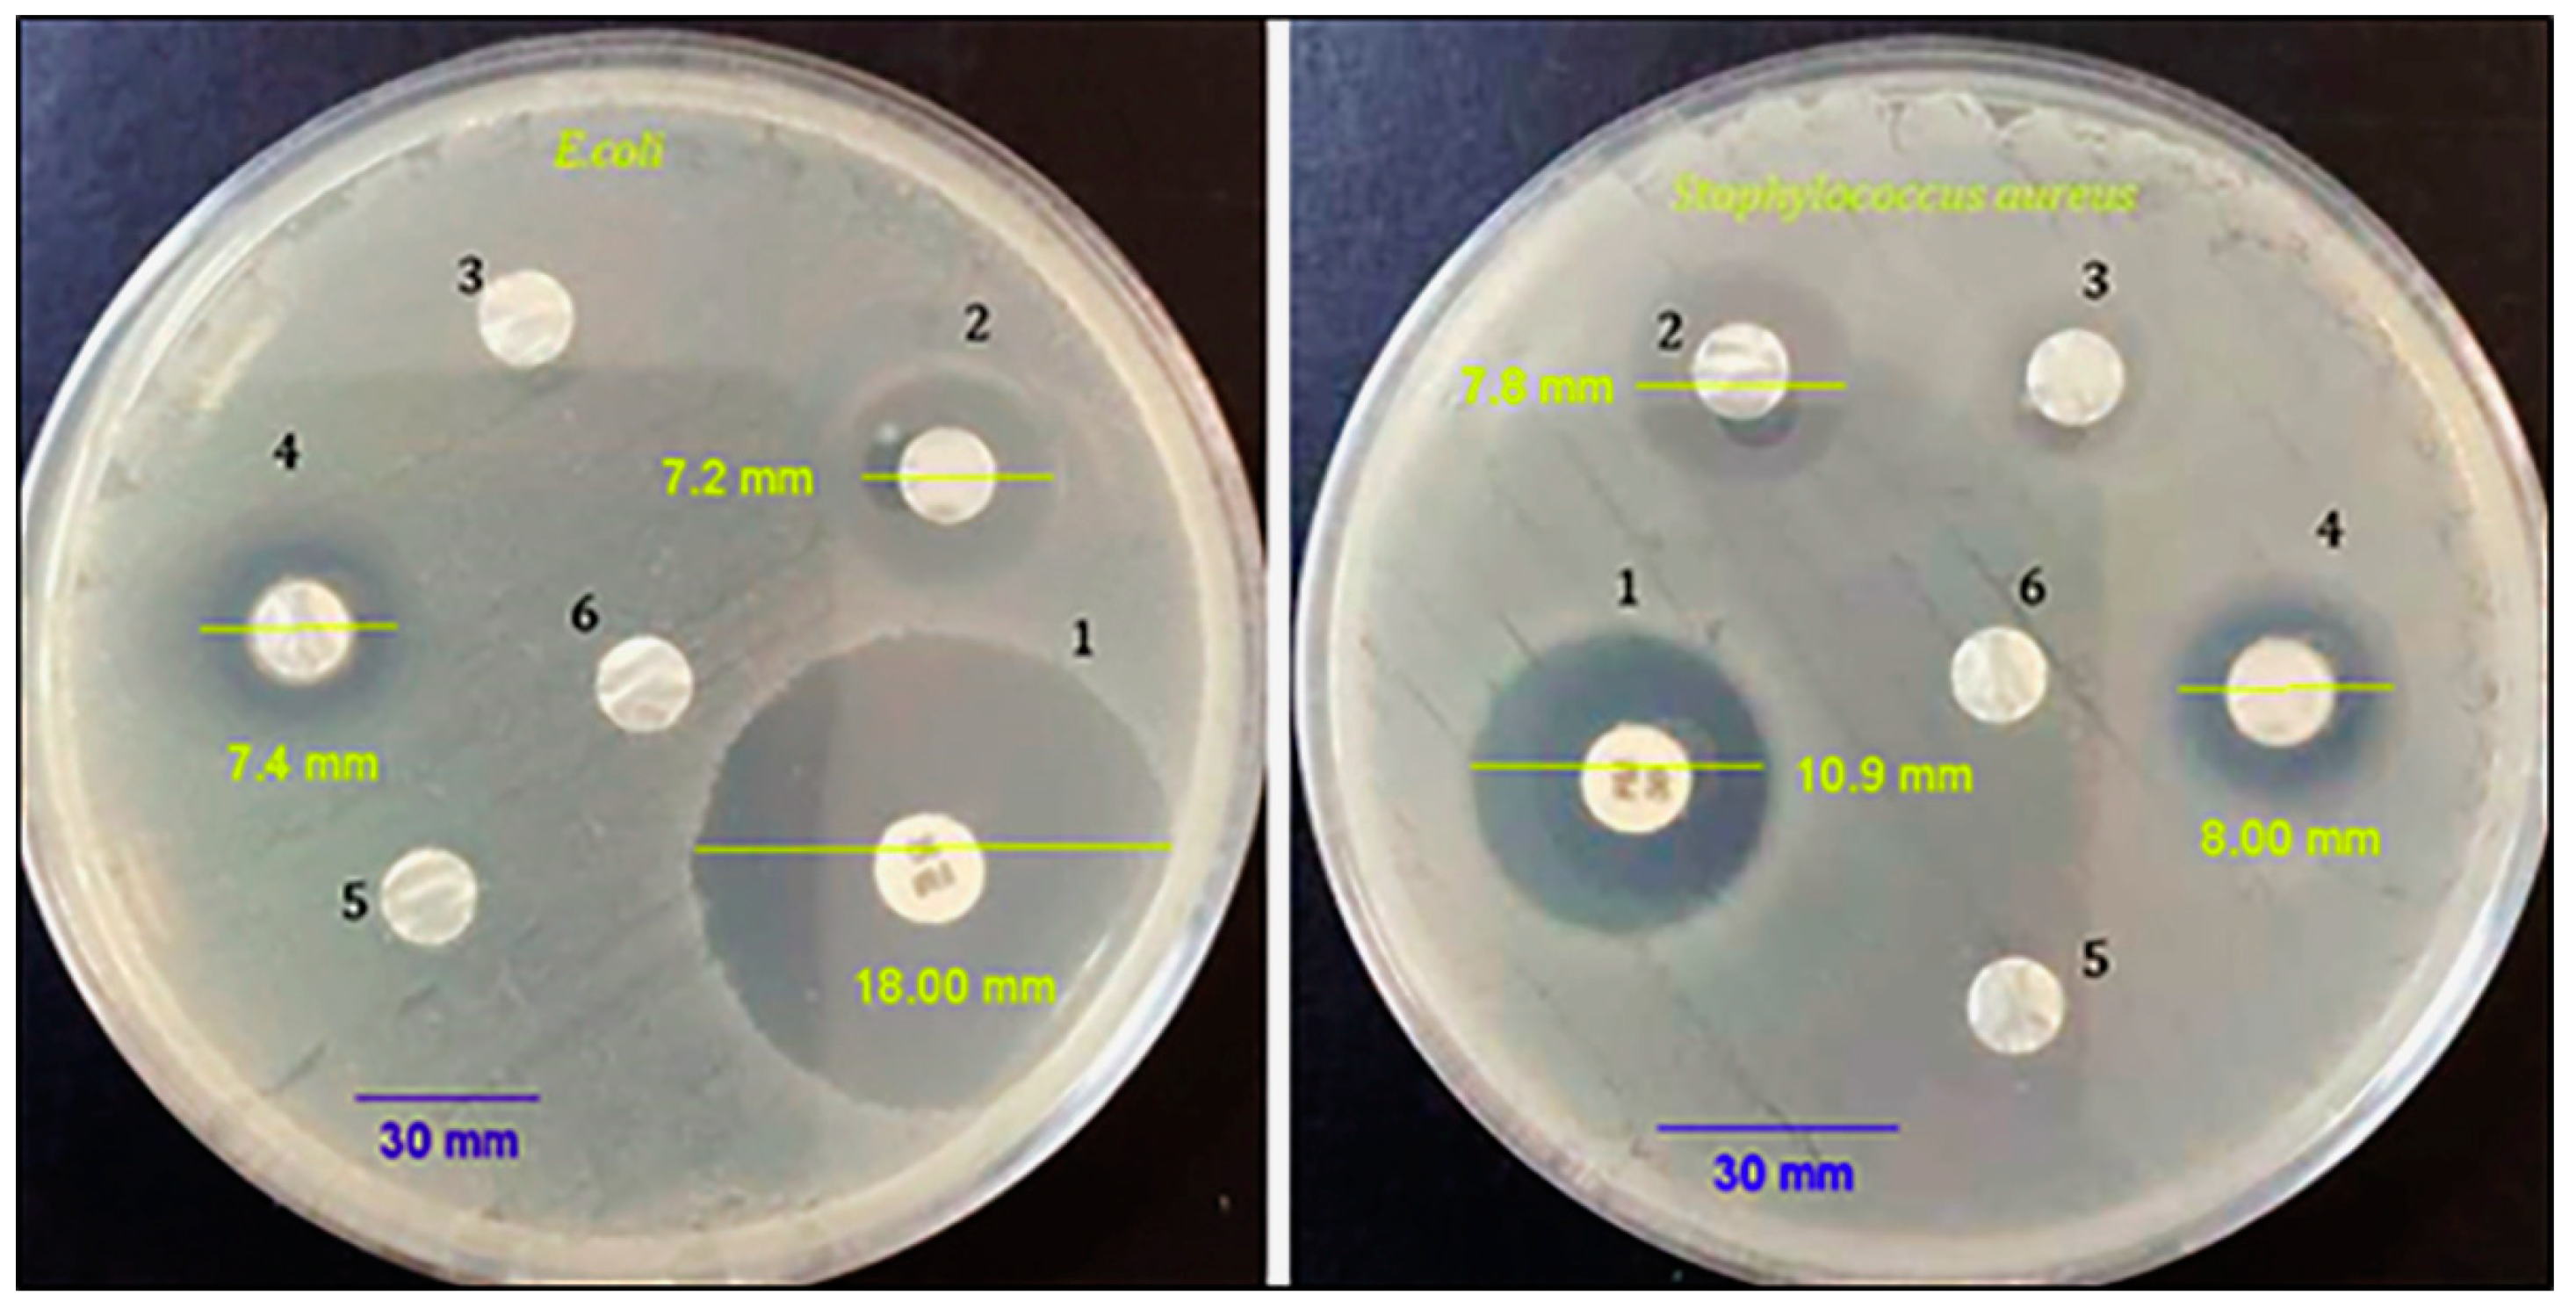
Biotech 12 00019 g005 Biotech 12 00019 g005

Fabrication of a Polycaprolactone/Chitosan Nanofibrous Scaffold Loaded with Nigella sativa Extract for Biomedical Applications
Abstract
1. Introduction
2. Materials and Methods
2.1. Material
2.2. Gas Chromatography–Mass Spectrometry (GC–MS) Analysis
2.3. Production of the Electrospun PCL, CS, and NS Nanofibrous Mats
2.4. Characterization of the PCL/CS/NS Nanofibrous Scaffold
2.4.1. Morphological Analysis Using SEM
2.4.2. Infrared Spectroscopy with Fourier Transform
2.4.3. Water Contact Angle and Mechanical Properties
2.5. In Vitro Cell Culture Studies
2.6. Antibacterial Activity
2.7. Activity of DPPH Radical Scavenging
3. Results and Discussion
3.1. GC–MS Analysis
3.2. Morphology of Nanofibers
3.3. FTIR Analysis
3.4. Water Contact Angle and Porosity Results
3.5. In Vitro Cell Culture Studies
3.6. Antibacterial Activity
3.7. Antioxidant Activity
4. Conclusions
Author Contributions
Funding
Institutional Review Board Statement
Informed Consent Statement
Data Availability Statement
Acknowledgments
Conflicts of Interest
References
- Medeiros, G.B.; Lima, F.d.A.; de Almeida, D.S.; Guerra, V.G.; Aguiar, M.L. Modification and Functionalization of Fibers Formed by Electrospinning: A Review. Membranes 2022, 12, 861. [Google Scholar] [CrossRef]
- Xue, J.; Wu, T.; Dai, Y.; Xia, Y. Electrospinning and Electrospun Nanofibers: Methods, Materials, and Applications. Chem. Rev. 2019, 119, 5298–5415. [Google Scholar]
- Albukhaty, S.; Al-Karagoly, H.; Allafchian, A.R.; Jalali, S.A.H.; Al-Kelabi, T.; Muhannad, M. Production and characterization of biocompatible nanofibrous scaffolds made of β-sitosterol loaded polyvinyl alcohol/tragacanth gum composites. Nanotechnology 2021, 33, 085102. [Google Scholar] [CrossRef]
- Castro, K.C.; Campos, M.G.N.; Mei, L.H.I. Hyaluronic Acid Electrospinning: Challenges, Applications in Wound Dressings and New Perspectives. Int. J. Biol. Macromol. 2021, 173, 251–266. [Google Scholar] [CrossRef] [PubMed]
- Han, D.K.; Park, K.D.; Hubbell, J.A.; Kim, Y.H. Surface Characteristics and Biocompatibility of Lactide-Based Poly(Ethylene Glycol) Scaffolds for Tissue Engineering. J. Biomater. Sci. Polym. Ed. 1998, 9, 667–680. [Google Scholar] [PubMed]
- Liu, H.; Gough, C.R.; Deng, Q.; Gu, Z.; Wang, F.; Hu, X. Recent Advances in Electrospun Sustainable Composites for Biomedical, Environmental, Energy, and Packaging Applications. Int. J. Mol. Sci. 2020, 21, 4019. [Google Scholar] [CrossRef] [PubMed]
- Katti, D.S.; Robinson, K.W.; Ko, F.K.; Laurencin, C.T. Bioresorbable nanofiber-based systems for wound healing and drug delivery: Optimization of fabrication parameters. J. Biomed. Mater. Res. Part B 2004, 70B, 286–296. [Google Scholar] [CrossRef] [PubMed]
- Chou, S.F.; Carson, D.; Woodrow, K.A. Current strategies for sustaining drug release from electrospun nanofibers. J. Controlled Release 2015, 220, 584–591. [Google Scholar] [CrossRef]
- Wang, C.; Wang, J.; Zeng, L.; Qiao, Z.; Liu, X.; Liu, H.; Zhang, J.; Ding, J. Fabrication of Electrospun Polymer Nanofibers with Diverse Morphologies. Molecules 2019, 24, 834. [Google Scholar] [CrossRef]
- Malikmammadov, E.; Tanir, T.E.; Kiziltay, A.; Hasirci, V.; Hasirci, N. PCL and PCL-based materials in biomedical applications. J. Biomater. Sci. Polym. Ed. 2018, 29, 863–893. [Google Scholar] [CrossRef]
- Bharadwaz, A.; Jayasuriya, A.C. Recent Trends in the Application of Widely Used Natural and Synthetic Polymer Nanocomposites in Bone Tissue Regeneration. Mater. Sci. Eng. C Mater. Biol. Appl. 2020, 110, 110698. [Google Scholar] [CrossRef] [PubMed]
- Mochane, M.J.; Motsoeneng, T.S.; Sadiku, E.R.; Mokhena, T.C.; Sefadi, J.S. Morphology and Properties of Electrospun PCL and Its Composites for Medical Applications: A Mini Review. Appl. Sci. 2019, 9, 2205. [Google Scholar] [CrossRef]
- Dulnik, J.; Denis, P.; Sajkiewicz, P.; Kolbuk, D.; Choińska, E. Biodegradation of biocomponent PCL/gelatin and PCL/collagen nanofibers electrospun from alternative solvent system. Polym. Degrad. Stab. 2016, 130, 10–21. [Google Scholar] [CrossRef]
- Wu, G.; Deng, X.; Song, J.; Chen, F. Enhanced biological properties of biomimetic apatite fabricated polycaprolactone/chitosan nanofibrous bio-composite for tendon and ligament regeneration. J. Photochem. Photobiol. B 2018, 178, 27–32. [Google Scholar] [CrossRef]
- Miguel, P.S.; Ribeiro, M.P.; Coutinho, P.; Correia, I.J. Electrospun polycaprolactone/aloe vera chitosan nanofibrous asymmetric membranes aimed for wound healing applications. Polymers 2017, 9, 183. [Google Scholar] [CrossRef] [PubMed]
- Al-Musawi, S.; Albukhaty, S.; Al-Karagoly, H.; Sulaiman, G.M.; Alwahibi, M.S.; Dewir, Y.H.; Soliman, D.A.; Rizwana, H. Antibacterial Activity of Honey/Chitosan Nanofibers Loaded with Capsaicin and Gold Nanoparticles for Wound Dressing. Molecules 2020, 25, 4770. [Google Scholar] [CrossRef]
- Mouro, C.; Simões, M.; Gouveia, I.C. Emulsion Electrospun Fiber Mats of PCL/PVA/Chitosan and Eugenol for Wound Dressing Applications. Adv. Polym. Technol. 2019, 2019, 9859506. [Google Scholar] [CrossRef]
- Asghari, F.; Rabiei Faradonbeh, D.; Malekshahi, Z.V.; Nekounam, H.; Ghaemi, B.; Yousefpoor, Y.; Ghanbari, H.; Faridi-Majidi, R. Hybrid PCL/Chitosan-PEO Nanofibrous Scaffolds Incorporated with A. Euchroma Extract for Skin Tissue Engineering Application. Carbohydr. Polym. 2022, 278, 118926. [Google Scholar] [CrossRef]
- Al-Attass, S.A.; Zahran, F.M.; Turkistany, S.A. Nigella sativa and its active constituent thymoquinone in oral health. Saudi Med. J. 2016, 37, 235–244. [Google Scholar] [CrossRef]
- Mekhemar, M.; Hassan, Y.; Dörfer, C. Nigella sativa and Thymoquinone: A Natural Blessing for Periodontal Therapy. Antioxidants 2020, 9, 1260. [Google Scholar] [CrossRef]
- Abu-Al-Basalc, M.A. In vitro and iin vivo anti-microbial effects of Nigella sativa Linn. seed extracts against clinical isolates from skin wound infections. Am. J. Appl. Sci. 2009, 6, 1440. [Google Scholar]
- Amin, B.; Hosseinzadeh, H. Black cumin (Nigella sativa) and its active constituent, thymoquinone: An overview on the analgesic and anti-inflammatory effects. Planta Med. 2016, 82, 8–16. [Google Scholar] [CrossRef] [PubMed]
- Ahmad, A.; Husain, A.; Mujeeb, M.; Khan, S.A.; Najmi, A.K.; Siddique, N.A.; Damanhouri, Z.A.; Anwar, F. A review on therapeutic potential of Nigella sativa: A miracle herb. Asian Pac. J. Trop. Biomed. 2013, 3, 337–352. [Google Scholar] [CrossRef] [PubMed]
- Toma, C.-C.; Olah, N.-K.; Vlase, L.; Mogoșan, C.; Mocan, A. Comparative Studies on Polyphenolic Composition, Antioxidant and Diuretic Effects of Nigella sativa L. (Black Cumin) and Nigella damascena L. (Lady-in-a-Mist) Seeds. Molecules 2015, 20, 9560–9574. [Google Scholar] [CrossRef]
- Jihad, M.A.; Noori, F.T.M.; Jabir, M.S.; Albukhaty, S.; AlMalki, F.A.; Alyamani, A.A. Polyethylene Glycol Functionalized Graphene Oxide Nanoparticles Loaded with Nigella sativa Extract: A Smart Antibacterial Therapeutic Drug Delivery System. Molecules 2021, 26, 3067. [Google Scholar] [CrossRef]
- Rooney, S.; Ryan, M.F. Effects of alpha-hederin and thymoquinone, constituents of Nigella sativa, on human cancer cell lines. Anticancer Res. 2005, 25, 2199–2204. [Google Scholar]
- Chaudhry, H.; Fatima, N.; Ahmad, I.Z. Evaluation of antioxidant and antibacterial potential of Nigella sativa L. suspension culture under elicitation. BioMed Res. Int. 2015, 5, 708691. [Google Scholar]
- Al-Ghamdi, M.S. The anti-inflammatory, analgesic and antipyretic activity of Nigella sativa. J. Ethnopharmacol. 2001, 76, 45–48. [Google Scholar] [CrossRef] [PubMed]
- Abd El-Hack, M.E.; Alagawany, M.; Farag, M.R.; Tiwari, R.; Karthik, K.; Dhama, K. Nutritional, healthical and therapeutic efficacy of black cumin (Nigella sativa) in animals, poultry and humans. Int. J. Pharmacol. 2016, 12, 232–248. [Google Scholar] [CrossRef]
- Abbas Ali, M.M.; Abu Sayeed, M.; Shahinur Alam, M.; Sarmina Yeasmin, A.; Mohal Khan, A.; Muhamad, I. Characteristics of oils and nutrient contents of Nigella sativa Linn. and Trigonella foenum-graecum seeds. Bull. Chem. Soc. Ethiop. 2012, 26, 55–64. [Google Scholar] [CrossRef]
- Teilaghi, S.; Movaffagh, J.; Bayat, Z. Preparation as Well as Evaluation of the Nanofiber Membrane Loaded with Nigella sativa Extract Using the Electrospinning Method. J. Polym. Environ. 2020, 28, 1614–1625. [Google Scholar] [CrossRef]
- Kalhori, F.; Arkan, E.; Dabirian, F.; Abdi, G.; Moradipour, P. Controlled preparation and characterization of Nigella sativa electrospun pad for controlled release. Silicon 2019, 15, 593–601. [Google Scholar] [CrossRef]
- Aras, C.; Tümay Özer, E.; Göktalay, G.; Saat, G.; Karaca, E. Evaluation of Nigella sativa oil loaded electrospun polyurethane nanofibrous mat as wound dressing. J. Biomater. Sci. Polym. Ed. 2021, 32, 1718–1735. [Google Scholar] [CrossRef]
- Mahmoudvand, H.; Asadi, A.; Harandi, M.F.; Sharififar, F.; Jahanbakhsh, S.; Dezaki, E.S. In vitro lethal effects of various extracts of Nigella sativa seed on hydatid cyst protoscoleces. Iran. J. Basic Med. Sci. 2014, 17, 1001. [Google Scholar] [PubMed]
- Zeer, A.; George, N. GC-MS analysis of n-hexane extract of Nigella sativa (seeds). Saudi J. Med. Pharm. Sci. 2017, 3, 868–872. [Google Scholar]
- Jabeen, N.S.; Jagapriya, L.; Balasubramanian, S.; Devi, K.; Jeevanandam, J. Phytochemical analysis of nigella sativa L. seeds aqueous extract by gas chromatography-mass spectroscopy and Fourier-transform infrared. In Phytochemistry; Apple Academic Press: Palm Bay, FL, USA, 2018; pp. 587–604. [Google Scholar]
- Reshmi, C.; Suja, P.; Manaf, O.; Sanu, P.; Sujith, A. Nanochitosan enriched poly ε-caprolactone electrospun wound dressing membranes: A fine tuning of physicochemical properties, hemocompatibility and curcumin release profile. Int. J. Biol. Macromol. 2018, 108, 1261–1272. [Google Scholar]
- Karim, A.M.; Kavehpour, H.P. Effect of viscous force on dynamic contact angle measurement using Wilhelmy plate method. Colloids Surf. A Physicochem. Eng. Asp. 2018, 548, 54–60. [Google Scholar] [CrossRef]
- Humphries, R.M.; Kircher, S.; Ferrell, A.; Krause, K.M.; Malherbe, R.; Hsiung, A.; Burnham, C.-A.D. The continued value of disk diffusion for assessing antimicrobial susceptibility in clinical laboratories: Report from the Clinical and Laboratory Standards Institute Methods Development and Standardization Working Group. J. Clin. Microbiol. 2018, 56, e00437-18. [Google Scholar] [CrossRef]
- Blois, M.S. Antioxidant determinations by the use of a stable free radical. Nature 1958, 181, 1199–1200. [Google Scholar] [CrossRef]
- Davoodbasha, M.; Edachery, B.; Nooruddin, T.; Lee, S.Y.; Kim, J.W. An evidence of C16 fatty acid methyl esters extracted from microalga for effective antimicrobial and antioxidant property. Microb. Pathog. 2018, 115, 233–238. [Google Scholar] [CrossRef]
- Devasagayam, T.P.A.; Tilak, J.C.; Boloor, K.K.; Sane, K.S.; Ghaskadbi, S.S.; Lele, R.D. Free radicals and antioxidants in human health: Current status and future prospects. J. Assoc. Physicians India 2004, 52, 4. [Google Scholar]
- Ukwubile, C.A.; Ahmed, A.; Katsayal, U.A.; Yau, J.; Mejida, S. GC-MS analysis of bioactive from Melastomastrum capitatum Fern. Leaf methanol extract. An anticancer plant. Sci. Afr. 2019, 3, 900e. [Google Scholar] [CrossRef]
- Dalli, M.; Bekkouch, O.; Azizi, S.-e.; Azghar, A.; Gseyra, N.; Kim, B. Nigella sativa L. Phytochemistry and Pharmacological Activities: A Review (2019–2021). Biomolecules 2022, 12, 20. [Google Scholar] [CrossRef] [PubMed]
- Das, U.N. Essential fatty acids: Biochemistry, physiology and pathology. Biotechnol. J. 2006, 1, 420–439. [Google Scholar] [CrossRef] [PubMed]
- Feng, J.J. The stretching of an electrified non-Newtonian jet: A model for electrospinning. Phys. Fluids 2002, 14, 3912–3926. [Google Scholar] [CrossRef]
- Sajeev, U.; Anand, K.A.; Menon, D.; Nair, S. Control of nanostructures in PVA, PVA/chitosan blends and PCL through electrospinning. Bull. Mater. Sci. 2008, 31, 343–351. [Google Scholar] [CrossRef]
- Narayanan, G.; Gupta, B.S.; Tonelli, A.E. Enhanced mechanical properties of poly (ε-caprolactone) nanofibers produced by the addition of non-stoichiometric inclusion complexes of poly (ε-caprolactone) and α-cyclodextrin. Polymer 2015, 76, 321–330. [Google Scholar] [CrossRef]
- Guo, R.; Wang, R.; Yin, J.; Jiao, T.; Huang, H.; Zhao, X.; Zhang, L.; Li, Q.; Zhou, J.; Peng, Q. Fabrication and Highly Efficient Dye Removal Characterization of Beta-Cyclodextrin-Based Composite Polymer Fibers by Electrospinning. Nanomaterials 2019, 9, 127. [Google Scholar] [CrossRef]
- Arif, U.; Haider, S.; Haider, A.; Khan, N.; Alghyamah, A.A.; Jamila, N.; Khan, M.I.; Almasry, W.A.; Kang, I.K. Biocompatible Polymers and their Potential Biomedical Applications: A Review. Curr. Pharm. Des. 2019, 25, 3608–3619. [Google Scholar] [CrossRef] [PubMed]
- Wang, H.M.; Yuan, T.Q.; Song, G.Y.; Sun, R.C. Advanced and Versatile Lignin-Derived Biodegradable Composite Film Materials toward a Sustainable World. Green Chem. 2021, 23, 3790–3817. [Google Scholar] [CrossRef]
- Bangar, S.P.; Whiteside, W.S. Nano-cellulose reinforced starch bio composite films- A review on green composites. Int. J. Biol. Macromol. 2021, 185, 849–860. [Google Scholar] [CrossRef]
- Pakravan, M.; Heuzey, M.C.; Ajji, A. A fundamental study of chitosan/PEO electrospinning. Polymer 2011, 52, 4813–4824. [Google Scholar] [CrossRef]
- Grant, J.J.; Pillai, S.C.; Perova, T.S.; Hehir, S.; Hinder, S.J.; McAfee, M.; Breen, A. Electrospun Fibres of Chitosan/PVP for the Effective Chemotherapeutic Drug Delivery of 5-Fluorouracil. Chemosensors 2021, 9, 70. [Google Scholar] [CrossRef]
- Shenoy, S.L.; Bates, W.D.; Frisch, H.L.; Wnek, G.E. Role of chain entanglements on fiber formation during electrospinning of polymer solutions: Good solvent, non-specific polymer-polymer interaction limit. Polymer 2005, 46, 3372–3384. [Google Scholar] [CrossRef]
- Roozbahani, F.; Sultana, N.; Ismail, A.F.; Nouparvar, H. Effects of Chitosan Alkali Pretreatment on the Preparation of Electrospun PCL/Chitosan Blend Nanofibrous Scaffolds for Tissue Engineering Application. J. Nanomater. 2013, 2013, 1. [Google Scholar] [CrossRef]
- Al-Kaabi, W.J.; Albukhaty, S.; Al-Fartosy, A.J.M.; Al-Karagoly, H.K.; Al-Musawi, S.; Sulaiman, G.M.; Dewir, Y.H.; Alwahibi, M.S.; Soliman, D.A. Development of Inula graveolens (L.) Plant Extract Electrospun/Polycaprolactone Nanofibers: A Novel Material for Biomedical Application. Appl. Sci. 2021, 11, 828. [Google Scholar] [CrossRef]
- Cerrone, F.; Pozner, T.; Siddiqui, A.; Ceppi, P.; Winner, B.; Rajendiran, M.; Babu, R.; Ibrahim, H.S.; Rodriguez, B.J.; Winkler, J.; et al. Polyhydroxyphenylvalerate/polycaprolactone nanofibers improve the life-span and mechanoresponse of human IPSC-derived cortical neuronal cells. Mater. Sci. Eng. C 2020, 111, 110832. [Google Scholar] [CrossRef]
- Thabede, P.M.; Shooto, N.D.; Xaba, T.; Naidoo, E.B. Magnetite functionalized Nigella sativa seeds for the uptake of chromium (VI) and lead (II) ions from synthetic wastewater. Adsorp. Sci. Technol. 2021, 2021, 6655227. [Google Scholar] [CrossRef]
- Gao, S.; Guo, W.; Chen, M.; Yuan, Z.; Wang, M.; Zhang, Y.; Liu, S.; Xi, T.; Guo, Q. Fabrication and characteriza-tion of electrospun nanofibers composed of decellularized meniscus extracellular matrix and polycaprolactone for meniscus tissue engineering. J. Mater. Chem. B 2017, 5, 2273–2285. [Google Scholar] [CrossRef] [PubMed]
- Zagórska-Dziok, M.; Bujak, T.; Ziemlewska, A.; Nizioł-Łukaszewska, Z. Positive Effect of Cannabis sativa L. Herb Extracts on Skin Cells and Assessment of Cannabinoid-Based Hydrogels Properties. Molecules 2021, 26, 802. [Google Scholar] [CrossRef]
- Zhang, L.; Zheng, T.; Wu, L.; Han, Q.; Chen, S.; Kong, Y.; Li, G.; Ma, L.; Wu, H.; Zhao, Y.; et al. Fabrication and Characterization of 3D-Printed Gellan Gum/Starch Composite Scaffold for Schwann Cells Growth. Nanotechnol. Rev. 2021, 10, 50–61. [Google Scholar] [CrossRef]
- Uddin, M.N.; Mohebbullah, M.; Islam, S.M.; Uddin, M.A.; Jobaer, M. Nigella/honey/garlic/olive oil co-loaded PVA electrospun nanofibers for potential biomedical applications. Prog. Biomater. 2022, 11, 431–446. [Google Scholar] [CrossRef] [PubMed]
- Shahverdi, F.; Barati, A.; Salehi, E.; Arjomandzadegan, M. Biaxial electrospun nanofibers based on chitosan-poly (vinyl alcohol) and poly (Ɛ-caprolactone) modified with CeAlO3 nanoparticles as potential wound dressing materials. Int. J. Biol. Macromol. 2022, 221, 736–750. [Google Scholar] [CrossRef] [PubMed]
- Karagoly, H.; Rhyaf, A.; Naji, H.; Albukhaty, S.; AlMalki, F.A.; Alyamani, A.A.; Albaqami, J.; Aloufi, S. Green synthesis, characterization, cytotoxicity, and antimicrobial activity of iron oxide nanoparticles using Nigella sativa seed extract. Green Process. Synth. 2022, 11, 254–265. [Google Scholar] [CrossRef]
- Jabir, M.S.; Rashid, T.M.; Nayef, U.M.; Albukhaty, S.; AlMalki, F.A.; Albaqami, J.; AlYamani, A.A.; Taqi, Z.J.; Sulaiman, G.M. Inhibition of Staphylococcus aureus α-hemolysin production using nanocurcumin capped Au@ZnO nanocomposite. Bioinorg. Chem. Appl. 2022, 2022, 1–18. [Google Scholar] [CrossRef]
- Yang, X.; Zhang, W.; Qin, X.; Cui, M.; Guo, Y.; Wang, T.; Wang, K.; Shi, Z.; Zhang, C.; Li, W.; et al. Recent Progress on Bioinspired Antibacterial Surfaces for Biomedical Application. Biomimetics 2022, 7, 88. [Google Scholar] [CrossRef]
- Bryk, R.; Lima, C.D.; Erdjument-Bromage, H.; Tempst, P.; Nathan, C. Metabolic enzymes of mycobacteria linked to antioxidant defense by a thioredoxin-like protein. Science 2002, 295, 1073–1077. [Google Scholar] [CrossRef] [PubMed]
- Adebayo, E.A.; Ibikunle, J.B.; Oke, A.M.; Lateef, A.; Azeez, M.A.; Oluwatoyin, A.O.; Ayanfe Oluwa, A.V.; Blessing, O.T.; Comfort, O.O.; Adekunle, O.O. Antimicrobial and antioxidant activity of silver, gold and silver-gold alloy nanoparticles phytosynthesized using extract of Opuntia ficus-indica. Rev. Adv. Mater. Sci. 2019, 58, 313–326. [Google Scholar] [CrossRef]
- Khane, Y.; Benouis, K.; Albukhaty, S.; Sulaiman, G.M.; Abomughaid, M.M.; Al Ali, A.; Aouf, D.; Fenniche, F.; Khane, S.; Chaibi, W.; et al. Green Synthesis of Silver Nanoparticles Using Aqueous Citrus limon Zest Extract: Characterization and Evaluation of Their Antioxidant and Antimicrobial Properties. Nanomaterials 2022, 12, 2013. [Google Scholar] [CrossRef] [PubMed]
- Gueffai, A.; Gonzalez-Serrano, D.J.; Christodoulou, M.C.; Orellana-Palacios, J.C.; Ortega, M.L.S.; Ouldmoumna, A.; Kiari, F.Z.; Ioannou, G.D.; Kapnissi-Christodoulou, C.P.; Moreno, A.; et al. Phenolics from Defatted Black Cumin Seeds (Nigella sativa L.): Ultrasound-Assisted Extraction Optimization, Comparison, and Antioxidant Activity. Biomolecules 2022, 12, 1311. [Google Scholar] [CrossRef]
- Vahitha, V.; Karim, R.; Perinbam, K.; Hossain, S.J.; Basha, S.K.; Karim, R. Demonstration of Antioxidant, Antibacterial and Antifungal Property of Nigella Sativa Seed Extract. East Afr. Scholars J. Agric. Life Sci 2019, 4472, 1–6. [Google Scholar]
- Arif, S.; Saqib, H.; Mubashir, M.; Malik, S.I.; Mukhtar, A.; Saqib, S.; Ullah, S.; Show, P.L. Comparison of Nigella sativa and Trachyspermum ammi via experimental investigation and biotechnological potential. Chem. Eng. Process.-Process Intensif. 2021, 161, 108313. [Google Scholar] [CrossRef]
- Ali, T.; Hussain, F.; Naeem, M.; Khan, A.; Al-Harrasi, A. Nanotechnology approach for exploring the enhanced bioactivities and biochemical characterization of freshly prepared nigella sativa L. nanosuspensions and their phytochemical profile. Front. Bioeng. Biotechnol. 2022, 10, 888177. [Google Scholar] [CrossRef] [PubMed]

| Peak No. | Ret. Time | Phytochemical Compounds | Molecular Formula | Molecular Weight | Peak Area % |
|---|---|---|---|---|---|
| 1 | 5.603 | Glycerin | C3H8O3 | 92 | 0.47 |
| 2 | 18.622 | Phenol, 2,4-bis(1,1-dimethylethyl)- | C14H22O | 206 | 0.18 |
| 3 | 20.18 | Phenol, 2,4-bis(1,1-dimethylethyl)- | C14H22O | 206 | 0.82 |
| 4 | 24.244 | Phenol, 2,4-bis(1,1-dimethylethyl)- | C14H22O | 206 | 0.93 |
| 5 | 35.471 | Hexadecanoic acid, methyl ester | C17H34O2 | 270 | 0.73 |
| 6 | 35.555 | 7,9-Di-tert-butyl-1-oxaspiro(4,5)deca-6,9-diene-2,8-dione | C17H24O3 | 276 | 0.15 |
| 7 | 35.807 | Hexadecanoic acid, methyl ester | C17H34O2 | 270 | 0.52 |
| 8 | 36.575 | l-(+)-Ascorbic acid 2,6-dihexadecanoate | C38H68O8 | 652 | 4.24 |
| 9 | 36.823 | Pentadecanoic acid | C15H30O2 | 242 | 3.73 |
| 10 | 37.284 | Hexadecanoic acid, ethyl ester | C17H34O2 | 270 | 0.82 |
| 11 | 37.511 | Hexadecanoic acid, ethyl ester | C17H34O2 | 270 | 0.52 |
| 12 | 39.765 | 9,12-Octadecadienoic acid (Z,Z)-, methyl ester | C19H34O2 | 294 | 5.07 |
| 13 | 39.925 | 10,13-Eicosadienoic acid, methyl ester | C21H38O2 | 322 | 6.46 |
| 14 | 40.066 | 9-Octadecenoic acid (Z)-, methyl ester | C19H36O2 | 296 | 1.89 |
| 15 | 40.573 | Methyl stearate | C19H38O2 | 298 | 0.23 |
| 16 | 41.125 | Octadec-9-enoic acid | C18H34O2 | 282 | 47.64 |
| 17 | 41.386 | 9,12-Octadecadienoic acid, ethyl ester | C20H36O2 | 308 | 7.71 |
| 18 | 41.485 | 9,12-Octadecadienoic acid, ethyl ester | C20H36O2 | 308 | 16.71 |
| 19 | 42.183 | Heptadecanoic acid, 15-methyl-, ethyl ester | C20H40O2 | 312 | 0.85 |
| 20 | 42.26 | Heptadecanoic acid, 15-methyl-, ethyl ester | C20H40O2 | 312 | 0.32 |
| Sample | Solutions: Ratio | Contact Angle (°) (Hydrophilicity) | FR (mL/h) | TCD (cm) | Voltage (kV) |
|---|---|---|---|---|---|
| PCL | - | 122.5° ± 2.0 | 0.5 | 20 | 20 |
| PC L/Cs | 99.6° ± 4.0 | 0.5 | 20 | 20 | |
| PCL/Cs/NS | 70:30 | 53.2 ± 1.0 | 0.5 | 20 | 20 |
| Sample | Ultimate Tensile Strength (MPa) | Contact Angle (°) (Hydrophilicity) |
|---|---|---|
| PCL | 1.8 ± 0.1 | 117.5 ± 2.0 |
| PCL/Cs/NS | 5.4 ± 0.2 * | 121.8 ± 2.0 * |
| PCL/Cs | 3.4 ± 0.1 | 118.2 ± 2.0 |
| Concentration (µg/mL) | CS % | NS % | NF % | Ascorbic Acid % |
|---|---|---|---|---|
| 10 | 20.079 | 18.108 | 40.986 | 41.23 |
| 20 | 29.787 | 30.63 | 42.342 | 50.01 |
| 30 | 41.935 | 37.903 | 50 | 57.14 |
| 40 | 46.825 | 49.206 | 56.349 | 68.74 |
| 50 | 49.107 | 53.968 | 63.492 | 77.18 |
| 60 | 60.15 | 63.888 | 74.306 | 84.94 |
| 70 | 67.123 | 68.211 | 79.47 | 91.41 |
| 80 | 75.159 | 77.844 | 83.832 | 96.01 |
| 90 | 79.289 | 80.662 | 87.845 | 99.01 |
| 100 | 80.829 | 84.455 | 94.81865 | 99.44 |
| Mean | 55.02 A | 56.48 AB | 67.34 AB | 76.51 B |
| SD | 20.99 * | 22.51 * | 19.43 * | 21.31 * |
| LSD (p < 0.05) = | 19.13 | |||
Disclaimer/Publisher’s Note: The statements, opinions and data contained in all publications are solely those of the individual author(s) and contributor(s) and not of MDPI and/or the editor(s). MDPI and/or the editor(s) disclaim responsibility for any injury to people or property resulting from any ideas, methods, instructions or products referred to in the content. |
© 2023 by the authors. Licensee MDPI, Basel, Switzerland. This article is an open access article distributed under the terms and conditions of the Creative Commons Attribution (CC BY) license (https://creativecommons.org/licenses/by/4.0/).
Share and Cite
Kahdim, Q.S.; Abdelmoula, N.; Al-Karagoly, H.; Albukhaty, S.; Al-Saaidi, J. Fabrication of a Polycaprolactone/Chitosan Nanofibrous Scaffold Loaded with Nigella sativa Extract for Biomedical Applications. BioTech 2023, 12, 19. https://doi.org/10.3390/biotech12010019
Kahdim QS, Abdelmoula N, Al-Karagoly H, Albukhaty S, Al-Saaidi J. Fabrication of a Polycaprolactone/Chitosan Nanofibrous Scaffold Loaded with Nigella sativa Extract for Biomedical Applications. BioTech. 2023; 12(1):19. https://doi.org/10.3390/biotech12010019
Chicago/Turabian StyleKahdim, Qasim Shakir, Najmeddine Abdelmoula, Hassan Al-Karagoly, Salim Albukhaty, and Jabbar Al-Saaidi. 2023. "Fabrication of a Polycaprolactone/Chitosan Nanofibrous Scaffold Loaded with Nigella sativa Extract for Biomedical Applications" BioTech 12, no. 1: 19. https://doi.org/10.3390/biotech12010019
APA StyleKahdim, Q. S., Abdelmoula, N., Al-Karagoly, H., Albukhaty, S., & Al-Saaidi, J. (2023). Fabrication of a Polycaprolactone/Chitosan Nanofibrous Scaffold Loaded with Nigella sativa Extract for Biomedical Applications. BioTech, 12(1), 19. https://doi.org/10.3390/biotech12010019

